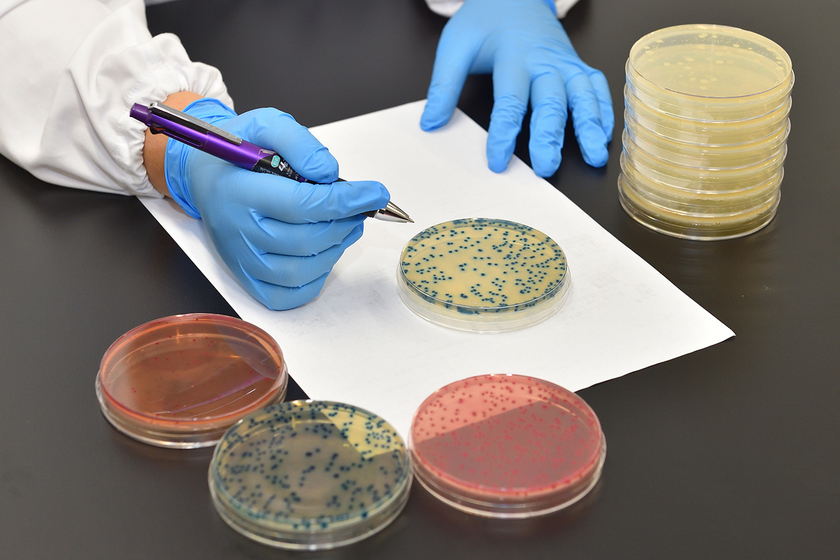

検査業務には、正確さと手早さの両方が求められます
食品や医薬品、化粧品などに含まれる菌の状況を調べる微生物検査を行っています。西日本各地の営業所から届く検体を処理し、ピペットでシャーレの寒天培地に分注するチームと、増殖させた微生物の数をカウントして成績書を作成するチームに分かれて作業を進めます。午前中に積み上がった800~900枚のシャーレがどんどん減って視界が広がり、すべての処理と掃除まで終業時間までに完了させることができた時の達成感は格別です。微生物検査は、多くの人々の安全や安心を裏側で支える、縁の下の力持ち的な存在。そんな大切な仕事を通じて世の中に貢献できていることは、とても誇らしく、いつも大きな意義を実感しています。
現在入社6年目で、チーム内では中堅的なポジションになりました。検査業務はもちろん、成績書の発送や後輩の指導など、仕事の幅も広がっています。当社では企業様の検査員向けの研修も行っており、私は補助員として参加。社内の研修施設だけでなく、企業様の工場まで出張して、現地で直接、実技指導などを行うこともあります。まだまだ経験不足を感じることもありますが、自分自身の学びにもなる良い刺激をもらっています。目標は早く補助員を卒業して、一人で研修全体を任せてもらえるようになること。後輩社員の指導経験を活かしながら、微生物検査の知識や技術をもっと分かりやすく説明し、やさしく伝えられるよう頑張りたいです。

検査員研修ではピペットなどの取り扱いから指導します
食の安全を守る仕事があることを知り、分析という仕事に興味を持ち、日本分析化学専門学校に入学しました。学校で学んだ菌の培養やグラム染色などの基礎知識は、今の仕事でも役立っていると感じます。また、道頓堀川の水質調査で大腸菌群を検査する緑色の培地は、職場で使用しているものと同じだったりと、プロの化学分析と同じレベルの実験を学生時代に経験できたのはよかったですね。就職のきっかけは、2年の春に学校から参加した企業見学会。希望する分野の仕事ができる企業への就職が叶い、とてもうれしかったです。同じ課で頑張っている同級生もいますし、先輩方にも日本分析化学専門学校の卒業生が多く、いつも頼りにしています。
試薬に反応した微生物の数を数え、規定値と照合します

アース環境サービス(株)彩都総合研究所 勤務/健康化学分析学科/2020年卒業/総合環境衛生管理事業という専門性の高いサービスを展開する企業の分析センターに勤務する山中さんは、西日本ラボのチーフ。「遺伝子、異物、微生物の3つの検査部門のなかで、私は入社以来ずっと微生物部門に所属しています。暑い季節は食中毒などの問題も発生しがちなので、処理数も増えてかなり忙しいです。チームのみんなと協力して、終業時間までにすべての作業を終わらせることを目標に頑張っています」。そんな彼女の趣味は、旅行や食べ歩き。研修では地方への出張の機会もあり、仕事終わりに出張先の名産や美味しいものに出会うのが楽しみだそう。
※この画面の情報は、すべて取材した時点でのものになります。



